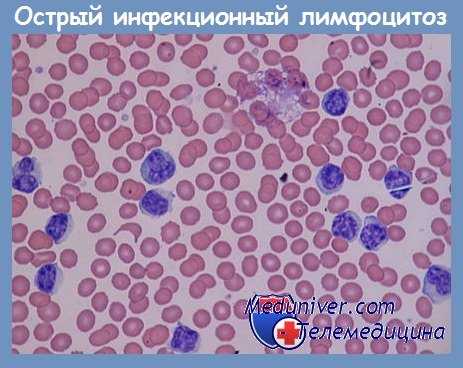
Острый инфекционный лимфоцитоз
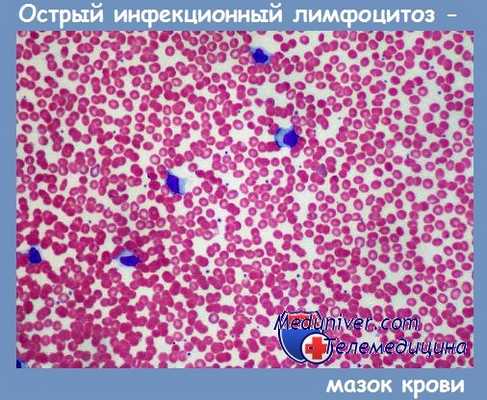
мазок крови при остром инфекционном лимфоцитозе

Лабораторная диагностика инфекционного лимфоцитоза - анализы
Добавил пользователь Алексей Ф. Обновлено: 03.12.2025
Лимфоцитопения (лимфопения) – это снижение уровня лимфоцитов менее 1 800 (18% от общего числа лейкоцитов) в 1 мкл крови. У детей из-за физиологического лимфоцитоза вследствие лейкоцитарного перекреста лимфоцитопенией признан показатель ниже 3 500-4 500. Причиной считаются инфекционные и аутоиммунные заболевания, злокачественные болезни крови. Клиническая картина определяе тся основной патологией. Лимфопения может проявляться гипоплазией миндалин глоточного кольца, активацией оппортунистических инфекций. Концентрация лимфоцитов измеряется в общем анализе крови (ОАК). Для их возврата к нормальным показателям необходимо лечение заболевания, послужившего причиной возникновения лимфоцитопении.
Классификация
Пороговых цифровых значений для разделения лимфоцитопении по степени тяжести не существует, условно выделяют умеренную и тяжелую. По отношению лимфоцитов к другим видам лейкоцитов различают следующие виды лимфоцитопении:
- Относительная. Снижение процентного содержания лимфоцитов в лейкоцитарной формуле меньше 18% при сохранении их нормального количества.
- Абсолютная. Уменьшение количества лимфоцитов в крови ниже 1 800.
Причины лимфоцитопении
Физиологические процессы
Лимфоцитопения не обязательно является признаком какого-либо заболевания. Причиной могут быть различные физиологические состояния, например, продолжительный стресс. При стрессе в кровь выделяются гормоны надпочечников (глюкокортикостероиды), обладающие разрушительным влиянием на лимфоциты. Лимфоцитопения также может наблюдаться при дефиците белка, поэтому нередко встречается при голодании или у людей, придерживающихся вегетарианской либо веганской диеты.
Вирусные инфекции
Под действием некоторых лимфотропных вирусов происходит ускоренная гибель лимфоцитов. Наиболее распространенной и опасной инфекционной причиной лимфоцитопении является вирус иммунодефицита человека (ВИЧ). Он связывается со специальными рецепторами (CD4) на поверхности Т-лимфоцитов (Т-хелперов), проникает внутрь клетки, где активно размножается и приводит к ее гибели. Снижение количества Т-хелперов происходит как за счет прямого повреждающего действия вируса, так и вследствие активации апоптоза (запрограммированной клеточной смерти) и аутоиммунного поражения.
В самом начале инфицирования уровень лимфоцитов может, наоборот, возрастать с развитием лейкоцитоза как иммунная реакция на чужеродный микроорганизм, но затем следует стремительное падение концентрации белых кровяных клеток вплоть до их полного отсутствия, с чем связано развитие синдрома приобретенного иммунодефицита, повышенной восприимчивости организма пациента к различным инфекциям, в том числе оппортунистическим. Лимфоцитопения может начать регрессировать только после длительной антиретровирусной терапии.
Кроме того, разрушению лимфоцитов способствуют следующие вирусные инфекции, при которых лимфоцитопения выражена намного меньше, чем при ВИЧ:
- Корь. Является частой причиной лимфоцитопении у детей. Вирус кори вызывает гибель фолликулярных В-лимфоцитов. Даже после выздоровления иммуносупрессия может сохраняться несколько недель или месяцев. Вирус кори также повреждает клетки иммунологической памяти, вызывая временную «иммунную амнезию».
- Респираторно-синцитиальная инфекция. Считается основной причиной поражения нижних дыхательных путей у младенцев и детей раннего возраста.
- Грипп. Развитие лимфоцитопении часто происходит у взрослых при тяжелом течении гриппа А1, свиного и птичьего гриппа. Ее возникновение – предиктор серьезных осложнений и неблагоприятного прогноза.
- SARS(острый респираторный синдром, атипичная пневмония). Возбудителем является коронавирус. Предполагается, что причиной лимфоцитопении становится индукция вирусом синдрома высвобождения цитокинов (цитокинового шторма), приводящего к гибели иммунных клеток.
Бактериальные инфекции
Причиной лимфоцитопении также могут стать некоторые бактериальные инфекции – лептоспироз, эрлихиоз, легионеллез. Наибольшую значимость имеет лимфопения при такой распространенной инфекции, как туберкулез (милиарный, диссеминированный). При этом заболевании наблюдается снижение Т-хелперов, Т-супрессоров (CD4, CD8 клеток). Патология встречается при септических состояниях (бактериальном заражении крови). Абсолютная лимфоцитопения свидетельствует о неблагоприятном течении любой бактериальной инфекции. Показатели достаточно быстро приходят в норму после проведения антибактериальной и противотуберкулезной терапии.

Аутоиммунные заболевания
Еще одной причиной лимфоцитопении выступают хронические воспалительные заболевания аутоиммунного характера. В ходе многочисленных исследований было обнаружено два основных патогенетических механизма лимфопении при этих патологиях – выделение антилимфоцитарных антител и снижение экспрессии на мембранах иммунных клеток специальных протеинов (CD55, CD59), защищающих клетки от комплемент-опосредованного цитолиза. Лимфоцитопения обычно умеренная, может коррелировать с тяжестью болезни, регрессирует во время ремиссии или под влиянием патогенетического лечения.
- Заболевания суставов.Ревматоидный артрит.
- Диффузные болезни соединительной ткани (коллагенозы). Системная красная волчанка, синдром Шегрена.
- Системные васкулиты. Гранулематоз с полиангиитом, неспецифический аортоартериит Такаясу.
- Воспалительные заболевания кишечника (ВЗК). Неспецифический язвенный колит, болезнь Крона.
- Рассеянный склероз.
Лимфопролиферативные заболевания
Онкогематологические патологии, такие как лимфогранулематоз (лимфома Ходжкина), Т-В-клеточные лимфомы, лимфосаркомы, тоже могут являться причиной лимфоцитопении. Обычно она развивается на поздних стадиях болезни и считается одним из критериев неблагоприятного исхода. Падение уровня лимфоцитов обусловлено истощением лимфоидной ткани и замещением гемопоэтической ткани атипичными злокачественными клетками.
Редкие причины
- Угнетение лимфоцитообразования: наследственные иммунодефициты (синдром Вискотта-Олдрича, синдром Ди Джорджи), заболевания, сопровождающиеся замещением лимфоидной ткани эпителиоидными гранулемами (саркоидоз, гистиоцитоз Х), воздействие ионизирующего излучения, апластическая анемия.
- Потери лимфы: повреждения крупных лимфатических протоков при травмах и полостных операциях, массивные ожоги, первичная кишечная лимфангиэктазия (болезнь Вальдмана).
- Ускоренное разрушение лимфоцитов: эндокринные расстройства (болезнь и синдром Иценко-Кушинга, сахарный диабет 1 типа), терминальная стадия хронической почечной недостаточности.
- Использование лекарственных препаратов: глюкокортикостероиды, иммуносупрессанты (метотрексат, азатиоприн), моноклональные антитела.
- Заболевания с неизвестным механизмом лимфоцитопении: злокачественные новообразования – рак молочной железы, щитовидной железы, прямой кишки.
Диагностика
Уровень лимфоцитов измеряется при подсчете лейкоцитарной формулы в клиническом анализе крови. Поскольку спектр заболеваний, которые могут быть причиной лимфопении, достаточно широк, при ее обнаружении следует обратиться к врачу для детального обследования. На основании клинических, анамнестических данных специалист составляет программу диагностических исследований, которая включает:
- Лабораторные анализы. Изучается как общее количество, так и процентное соотношение различных видов лейкоцитов. Определяется уровень маркеров воспаления – СОЭ, СРБ. Проверяется наличие аутоантител (АЦЦП, антител к ДНК, к цитоплазме нейтрофилов). При подозрении на сепсис измеряется прокальцитонин, пресепсин. При воспалительных патологиях кишечника в кале повышается содержание фекального кальпротектина. Исследуется концентрация сывороточных иммуноглобулинов (IgG, IgM, IgA).
- Микробиологические исследования. Для подтверждения туберкулеза проводится бактериологический посев и микроскопия мокроты, туберкулинодиагностика (проба Манту, диаскин-тест). Методом иммуноферментного анализа идентифицируются антитела к возбудителям (вирусам, бактериям). Верифицирующим тестом на ВИЧ-инфекцию является обнаружение белков оболочки вируса (gp120, gp41) при иммуноблоттинге.
- Инструментальные исследования. При туберкулезе на рентгенограммах легких отмечается увеличение лимфатических узлов (прикорневых, медиастинальных), инфильтрации верхних долей легких. На снимках суставов при ревматоидном артрите выявляется сужение суставной щели, краевые эрозии, остеопороз. При фиброколоноскопии у больных ВЗК находят гиперемию слизистой оболочки, участки изъязвления. На МРТ головного мозга при рассеянном склерозе видны очаги демиелинизации овальной формы размером 1-2 мм.
- Гистологические исследования. При исследовании материала, полученного путем биопсии лимфатического узла, у больных лимфопролиферативными заболеваниями отмечается диффузная пролиферация лимфоидных клеток, имеющих бластную морфологию, клетки Березовского-Штернберга. При системных васкулитах в биоптате обнаруживают периваскулярную инфильтрацию плазмоцитами, гистиоцитами.

Коррекция
Путей самостоятельного купирования лимфоцитопении не существует. Для нормализации уровня лимфоцитов нужно устранить причину, а именно – проводить лечение основной патологии. Если лимфоцитопения возникла на фоне стресса или дефицита белка в пищевом рационе, лечение не требуется, достаточно откорректировать диету. При стойкой длительной лимфопении необходимо медицинское вмешательство. В зависимости от причины применяются следующие мероприятия:
- Борьба с инфекцией. Для лечения ВИЧ-инфекции назначается антиретровирусная терапия – нуклеозидные ингибиторы обратной транскриптазы, ингибиторы протеазы (саквинавир). При гриппе показан осельтамивир. Для лечения остальных вирусных инфекций не существует этиотропных медикаментов, используются симптоматические методы (жаропонижающие средства, дезинтоксикационная терапия). При неспецифических бактериальных инфекциях рекомендованы антибиотики, при туберкулезе – комбинации противотуберкулезных средств (изониазид, рифампицин).
- Противовоспалительная терапия. Для достижения ремиссии аутоиммунных заболеваний применяются лекарственные препараты, подавляющие процесс воспаления – глюкокортикостероиды, синтетические производные аминохинолина и 5-аминосалициловой кислоты, иммуносупрессанты (метотрексат, циклофосфамид).
- Лечение лимфопролиферативных болезней. При лимфогранулематозе, неходжкинских лимфомах показана полихимиотерапия (винкристин, дакарбазин, этопозид). Эффективно облучение пораженных опухолью лимфатических узлов.
Прогноз
Лимфоцитопения достаточно часто является предиктором неблагоприятного прогноза, сопряжена с повышенным риском инфекционных заболеваний и активацией условно-патогенной микрофлоры. Исход и продолжительность жизни пациентов определяются основной патологией, на фоне которой возникла лимфопения. Наиболее доброкачественной является лимфоцитопения, развившаяся после длительного стресса или при белковом голодании. Наследственные иммунодефицитные состояния и онкогематологические болезни характеризуются большой вероятностью летального исхода в ранние сроки.
1. Лимфопения: основные причины развития/ Ватутин Н.Т., Ещенко Е.В.// Архивъ внутренней медицины. – 2016 - № 2(28).
2. Патофизиология системы крови. Часть II. Нарушения в системе лейкоцитов/ Николаева О.В., Кучерявченко М.А., Шутова Н.А. и др. – 2016.
Лабораторная диагностика инфекционного лимфоцитоза - анализы
Острый инфекционный лимфоцитоз - история изучения, клиника
Синонимы острого инфекционного лимфоцитоза: болезнь Smith, острый асимптоматический доброкачественный лимфоцитоз, febris lymphocitica)
Острый инфекционный лимфоцитоз — острая эпидемическая гемолимфопатия, с мягким, доброкачественным течением, спонтанно самоограниченная, неизвестной, возможно вирусной этиологии, которая возникает преимцщественно у детей в первые десять лет жизни.
Гемопатологически болезнь характеризуется значительным гиперлейкоцитозом с гиперлимфоцитозом: клинически чаще всего асимптоматична или с нехарактерными инфекционными, диггестивными, дыхательными явлениями.
Этиология острого инфекционного лимфоцитоза точно неизвестна, но по всей вероятности имеет вирусную основу (Olson). В некоторых эпидемиях удалось выделить аденовирус типа 12, а в других — нетипизированный энтеровирус, подобный группе Coxsackie А, присутствующий у 21% больных и у 26,4% контактных лиц (Horowitz и сотр.).
Титр нейтрализирующих антител оказывался увеличенным в 4 раза у всех больных. Были взяты на учет, как возможные этиологические агенты, но без убедительных доказательств: Giardia, Lamblia и Listeria monocitogenes.
Эпидемиология острого инфекционного лимфоцитоза
Описываются микроэпидемии, наряду с отдельными случаями. Болезнь поражает преимущественно детей между 1 и 14 годами, с максимальной поражаемостью между 2 и 7 годами, и очень редко молодых взрослых. Повидимому пол не имеет значения. Частоту болезни невозможно установить, благодаря высокой частоте асимптоматических случаев, из которых лишь некоторые выявляются в результате случайной гемограммы.
Болезнь распространена во всем мире, но очевидно встречается чаще в умеренном поясе, особенно весной и осенью. Заражение происходит повидимому по носо-фарингеальному пути через капли Pfliigge. Период заразности неизвестен. Заразность как и восприимчивость кажется большей особенно в раннем и позднем детстве, а также и у молодых взрослых с анергизирующими заболеваниями в ближайшем прошлом.
Клиническая симптоматология острого инфекционного лимфоцитоза
Инкубационный период, около 2 недель, с пределами между 11 и 21 днем, полностью асимптоматичный.
Инвазивный период острого инфекционного лимфоцитоза в случаях с явными клиническими проявлениями, непродолжительный, между 12 и 24 часами, с проявлениями различной интенсивности, от медленных малосимптомных до резкого псевдогриппозного начала или с фебрильиым инфекционным синдромом, с острыми ринофарингитами. Реакция варьирует от одного индивида к другому, но является подобной в рамках одной и той же эпидемии. Более резкие вариации наблюдаются от одной эпидемии к другой.
Период разгара острого инфекционного лимфоцитоза водворяется быстро и продолжается от несколыких дней до 15—20 дней. Проявляется полиморфно и нехарактерно подлихорадкой или лихорадкой 38—39°С, реже 40°С, в течение 1—3—7 дней, раздражительностью, астенией, катарральной, ринофарингеальной ирринацией, к которым может добавляться одно из следующих явлений:
1) диггестивный синдром с тошнотами, рвотами, поносом (полужидкий стул, 4—7 раз в день); брюшные боли, которые могут доходить до симулирования острого живота;
2) инфекционный синдром верхних дыхательных путей;
3) кожный синдром с беглым коревидным, скарлатиновидным макропапулезным rash-ем;
4) гораздо реже неврологический синдром с миалгиями и менингеальными, энцефалическими проявлениями, с доброкачественным течением;
5) переплетение маловыраженных признаков этих синдромов. Подавляющее большинство случаев повидимому остаются асимптоматичными, причем диагноз ставится в результате случайной гемограммы. Характерно отсутствие аденопатий вообще и гепатомегалии.
Конвалесценция острого инфекционного лимфоцитоза имеет вариабильную продолжительность, несколько короче у молодых взрослых.
Клинические формы острого инфекционного лимфоцитоза
В зависимости от наличия и интенсивности симптомов описываются: неявные (большинство), простые, средние, суровые (очень редко) клинические формы, а по клиническим синдромам, под которыми они могут проявляться, описываются: тифозная форма с высокой температурой и кожными высыпаниями; дыхательная форма с конъюнктиворинофаринготрахеобронхиальным катарром; гастроинтестинальная форма; форма с неврологическим синдромом, а также и ганглиозная форма (редкая) с дискретными до умеренных гипертрофиями, общими или локализированными, поверхностных или висцеральных лимфатических желез.
Течение острого инфекционного лимфоцитоза — доброкачественная в большинстве случаев как немедленно, так и позднее, без последствий. Вторичное обследование спустя 19 лет болезни 25 больных в результате эпидемии, насчитывавшей 31 случай, не обнаружило у них никакого сколько-нибудь значительного постэффекта (Smith).
Осложнения отмечаются лишь чрезвычайно редко, в виде наслоенных инфекций или обострения того или иного симптома. Прогноз — благоприятный.
Редактор: Искандер Милевски. Дата обновления публикации: 18.3.2021
Хронический лимфолейкоз
Хронический лимфолейкоз – это онкологическое заболевание, сопровождающееся накоплением атипичных зрелых В-лимфоцитов в периферической крови, печени, селезенке, лимфоузлах и костном мозге. На начальных стадиях проявляется лимфоцитозом и генерализованной лимфоаденопатией. При прогрессировании хронического лимфолейкоза наблюдаются гепатомегалия и спленомегалия, а также анемия и тромбоцитопения, проявляющиеся слабостью, утомляемостью, петехиальными кровоизлияниями и повышенной кровоточивостью. Отмечаются частые инфекции, обусловленные снижением иммунитета. Диагноз устанавливается на основании лабораторных исследований. Лечение – химиотерапия, пересадка костного мозга.
МКБ-10
Общие сведения
Хронический лимфолейкоз – заболевание из группы неходжкинских лимфом. Сопровождается увеличением количества морфологически зрелых, но неполноценных В-лимфоцитов. Хронический лимфолейкоз является самой распространенной формой гемобластозов, составляет треть всех лейкозов, диагностируемых в США и странах Европы. Мужчины страдают чаще женщин. Пик заболеваемости приходится на возраст 50-70 лет, в этом периоде выявляется около 70% от общего количества хронических лимфолейкозов.
Пациенты молодого возраста страдают редко, до 40 лет первые симптом болезни возникают всего у 10% больных. В последние годы специалисты отмечают некоторое «омоложение» патологии. Клиническое течение хронического лимфолейкоза очень вариативно, возможно как продолжительное отсутствие прогрессирования, так и крайне агрессивный вариант с летальным исходом в течение 2-3 лет после постановки диагноза. Существует ряд факторов, позволяющих прогнозировать течение заболевания. Лечение осуществляют специалисты в области онкологии и гематологии.
Причины
Причины возникновения окончательно не выяснены. Хронический лимфолейкоз считается единственным лейкозом с неподтвержденной связью между развитием заболевания и неблагоприятными факторами внешней среды (ионизирующим излучением, контактом с канцерогенными веществами). Специалисты считают, что основным фактором, способствующим развитию хронического лимфолейкоза, является наследственная предрасположенность. Типичные хромосомные мутации, вызывающие повреждения онкогенов на начальной стадии болезни, пока не выявлены, однако исследования подтверждают мутагенную природу заболевания.
Патогенез
Клиническая картина хронического лимфолейкоза обусловлена лимфоцитозом. Причиной лимфоцитоза становится появление большого количества морфологически зрелых, но иммунологически дефектных В-лимфоцитов, неспособных к обеспечению гуморального иммунитета. Ранее считали, что аномальные В-лимфоциты при хроническом лимфолейкозе являются долго живущими клетками и редко подвергаются делению. В последующем эта теория была опровергнута.
Исследования показали, что В-лимфоциты быстро размножаются. Ежедневно в организме больного образуется 0,1-1% от общего количества атипичных клеток. У разных больных поражаются различные клоны клеток, поэтому хронический лимфолейкоз можно рассматривать как группу близкородственных заболеваний с общим этиопатогенезом и сходной клинической симптоматикой.
При изучении клеток выявляется большое разнообразие. В материале могут преобладать широкоплазменные либо узкоплазменные клетки с молодыми либо сморщенными ядрами, почти бесцветной либо ярко окрашенной зернистой цитоплазмой. Пролиферация аномальных клеток происходит в псевдофолликулах – скоплениях лейкозных клеток, располагающихся в лимфоузлах и костном мозге.
Причинами цитопении при хроническом лимфолейкозе являются аутоиммунное разрушение форменных элементов крови и подавление пролиферации стволовых клеток, обусловленное повышением уровня Т-лимфоцитов в селезенке и периферической крови. Кроме того, при наличии киллерных свойств разрушение кровяных клеток могут вызывать атипичные В-лимфоциты.
С учетом симптомов, морфологических признаков, скорости прогрессирования и реакции на терапию различают следующие формы болезни:
- Хронический лимфолейкоз с доброкачественным течением. Состояние больного долго остается удовлетворительным. Отмечается медленное увеличение количества лейкоцитов в крови. С момента постановки диагноза до стабильного увеличения лимфоузлов может пройти несколько лет или даже десятилетий. Больные сохраняют трудоспособность и привычный образ жизни.
- Классическая (прогрессирующая) форма хронического лимфолейкоза. Лейкоцитоз нарастает в течение месяцев, а не лет. Отмечается параллельное увеличение лимфоузлов.
- Опухолевая форма хронического лимфолейкоза. Отличительной особенностью этой формы является нерезко выраженный лейкоцитоз при выраженном увеличении лимфоузлов.
- Костномозговая форма хронического лимфолейкоза. Выявляется прогрессирующая цитопения при отсутствии увеличения лимфатических узлов, печени и селезенки.
- Хронический лимфолейкоз с увеличением селезенки.
- Хронический лимфолейкоз с парапротеинемией. Отмечаются симптомы одной из вышеперечисленных форм заболевания в сочетании с моноклональной G- или M-гаммапатией.
- Прелимфоцитарная форма хронического лимфолейкоза. Отличительной особенностью этой формы является наличие лимфоцитов, содержащих нуклеолы, в мазках крови и костного мозга, образцах ткани селезенки и лимфоузлов.
- Волосатоклеточный лейкоз. Выявляются цитопения и спленомегалия при отсутствии увеличения лимфоузлов. При микроскопическом исследовании обнаруживаются лимфоциты с характерным «моложавым» ядром и «неровной» цитоплазмой с обрывами, фестончатыми краями и ростками в виде волосков либо ворсинок.
- Т-клеточная форма хронического лимфолейкоза. Наблюдается в 5% случаев. Сопровождается лейкемической инфильтрацией дермы. Обычно быстро прогрессирует.
Выделяют три стадии клинических стадии хронического лимфолейкоза: начальную, развернутых клинических проявлений и терминальную.
Симптомы хронического лимфолейкоза
На начальной стадии патология протекает бессимптомно и может выявляться только по анализам крови. В течение нескольких месяцев или лет у больного хроническим лимфолейкозом выявляется лимфоцитоз 40-50%. Количество лейкоцитов приближено к верхней границе нормы. В обычном состоянии периферические и висцеральные лимфоузлы не увеличены. В период инфекционных заболеваний лимфатические узлы могут временно увеличиваться, а после выздоровления снова уменьшаться. Первым признаком прогрессирования хронического лимфолейкоза становится стабильное увеличение лимфоузлов, нередко – в сочетании с гепатомегалией и спленомегалией.
Вначале поражаются шейные и подмышечные лимфоузлы, затем – узлы в области средостения и брюшной полости, потом – в паховой области. При пальпации выявляются подвижные безболезненные плотноэластические образования, не спаянные с кожей и близлежащими тканями. Диаметр узлов при хроническом лимфолейкозе может колебаться от 0,5 до 5 и более сантиметров. Крупные периферические лимфоузлы могут выбухать с образованием видимого косметического дефекта. При значительном увеличении печени, селезенки и висцеральных лимфоузлов может наблюдаться сдавление внутренних органов, сопровождающееся различными функциональными нарушениями.
Пациенты с хроническим лимфолейкозом жалуются на слабость, беспричинную утомляемость и снижение трудоспособности. По анализам крови отмечается увеличение лимфоцитоза до 80-90%. Количество эритроцитов и тромбоцитов обычно остается в пределах нормы, у некоторых больных выявляется незначительная тромбоцитопения. На поздних стадиях хронического лимфолейкоза отмечаются снижение веса, ночные поты и повышение температуры до субфебрильных цифр. Характерны расстройства иммунитета. Больные часто страдают простудными заболеваниями, циститом и уретритом. Наблюдается склонность к нагноению ран и частое образование гнойников в подкожной жировой клетчатке.
Причиной летального исхода при хроническом лимфолейкозе часто становятся тяжелые инфекционные заболевания. Возможны воспаления легких, сопровождающиеся спаданием легочной ткани и грубыми нарушениями вентиляции. У некоторых больных развивается экссудативный плеврит, который может осложняться разрывом или сдавлением грудного лимфатического протока. Еще одним частым проявлением развернутого хронического лимфолейкоза является опоясывающий лишай, который в тяжелых случаях становится генерализованным, захватывая всю поверхность кожи, а иногда и слизистые оболочки. Аналогичные поражения могут наблюдаться при герпесе и ветряной оспе.
Осложнения
В числе возможных осложнений хронического лимфолейкоза – инфильтрация преддверно-улиткового нерва, сопровождающаяся расстройствами слуха и шумом в ушах. В терминальной стадии хронического лимфолейкоза может наблюдаться инфильтрация мозговых оболочек, мозгового вещества и нервных корешков. По анализам крови выявляются тромбоцитопения, гемолитическая анемия и гранулоцитопения.
Возможна трансформация хронического лимфолейкоза в синдром Рихтера – диффузную лимфому, проявляющуюся быстрым ростом лимфоузлов и формированием очагов за пределами лимфатической системы. До развития лимфомы доживает около 5% пациентов. В остальных случаях смерть наступает от инфекционных осложнений, кровотечений, анемии и кахексии. У некоторых больных хроническим лимфолейкозом развивается тяжелая почечная недостаточность, обусловленная инфильтрацией почечной паренхимы.
В половине случаев патологию обнаруживают случайно, при обследовании по поводу других заболеваний или при проведении планового осмотра. При постановке диагноза учитывают жалобы, анамнез, данные объективного осмотра, результаты анализов крови и иммунофенотипирования. Диагностическим критерием хронического лимфолейкоза является увеличение количества лейкоцитов в анализе крови до 5×109/л в сочетании с характерными изменениями иммунофенотипа лимфоцитов. При микроскопическом исследовании мазка крови выявляются малые В-лимфоциты и тени Гумпрехта, возможно – в сочетании с атипичными или крупными лимфоцитами. При иммунофенотипировании подтверждается наличие клеток с абберантным иммунофенотипом и клональность.
Определение стадии хронического лимфолейкоза осуществляют на основании клинических проявлений заболевания и результатов объективного осмотра периферических лимфоузлов. Для составления плана лечения и оценки прогноза при хроническом лимфолейкозе проводят цитогенетические исследования. При подозрении на синдром Рихтера назначают биопсию. Для определения причин цитопении выполняют стернальную пункцию костного мозга с последующим микроскопическим исследованием пунктата.
Лечение хронического лимфолейкоза
На начальных стадиях хронического лимфолейкоза применяют выжидательную тактику. Пациентам назначают обследование каждые 3-6 месяцев. При отсутствии признаков прогрессирования ограничиваются наблюдением. Показанием к проведению активного лечения является увеличение количества лейкоцитов вдвое и более в течение полугода. Основным методом лечения хронического лимфолейкоза является химиотерапия. Наиболее эффективной комбинацией лекарственных препаратов обычно становится сочетание ритуксимаба, циклофосфамида и флударабина.
При упорном течении хронического лимфолейкоза назначают большие дозы кортикостероидов, осуществляют пересадку костного мозга. У больных пожилого возраста с тяжелой соматической патологией использование интенсивной химиотерапии и пересадка костного мозга могут быть затруднены. В подобных случаях проводят монохимиотерапию хлорамбуцилом или применяют данный препарат в сочетании с ритуксимабом.
Хронический лимфолейкоз рассматривается как практически неизлечимое длительно текущее заболевание с относительно удовлетворительным прогнозом. В 15% случаев наблюдается агрессивное течение с быстрым нарастанием лейкоцитоза и прогрессированием клинической симптоматики. Летальный исход при этой форме хронического лимфолейкоза наступает в течение 2-3 лет. В остальных случаях отмечается медленное прогрессирование, средняя продолжительность жизни с момента постановки диагноза колеблется от 5 до 10 лет. При доброкачественном течении срок жизни может составлять несколько десятилетий. После прохождения курса лечения улучшение наблюдается у 40-70% больных хроническим лимфолейкозом, однако полные ремиссии выявляются редко.
Лабораторная диагностика острого инфекционного лимфоцитоза. Лечение
Гемограмма при остром инфекционном лимфоцитозе показывает изменения белой серии, которые присутствуют всегда и тем самым характеризуют болезнь даже и в отсутствии клинической симптоматологии. Гиперлейкоцитоз колеблется между 30 000 и 40 000, доходя иногда и до 100 000/мм3. В качестве крайних пределов — 26 000—93 000/мм3 (Duncan) и 26 000—147 000/мм3 (Smith). У молодых взрослых можно наблюдать несколько меньшее количество: между 16 000 и 25 000 лейкоцитов/мм3 (Voiculescu).
Лейкоцитоз эволюирует начиная еще от дебюта, возрастая в течение периода разгара параллельно с лихорадкой, спадая затем медленно в течение 2—12 недель; в большинстве случаев исчезает за 3—7 недель.
В лейкоцитарной формуле преобладают малые лимфоциты, превышающие всегда 50% всех элементов, вариируя обычно между 60 и 95%. В абсолютных цифрах, они превышают вообще в 10—20 раз нормальное количество. С морфологической точки зрения это взрослые лимфоциты, нормального вида, малых размеров, с ядром из плотного темного хроматина и с малым количеством цитоплазмы, часто содержащей несколько азурофильных специфических грануляций (Raileanu).
Лимфоцитоз может продолжаться 15—30 дней или даже до 2—3 месяцев после исчезновения клинических явлений. В течение периода выздоровления может появляться легкая абсолютная эозинофилия, особенно сразу после того, как максимальная кривая лейкоцитов начинает спадать. Моноциты — нормальные с точки зрения числа и морфологии. Эритроциты и тромбоциты, как правило, не показывают отклонений от нормы.
Медуллограмма при остром инфекционном лимфоцитозе, обычно нормальная, может представлять легкий рост глобального количества клеток за счет нормальных лимфоцитов, которые могут достигать 30—40%.
Реакция оседания эритроцитов, нормальная или слегка повышенная до 15—30 мм/час (Marinescu).
Электрофорез при остром инфекционном лимфоцитозе, обычно нормальный, может показывать сперва понижение протеинемии с ее последующим ростом благодаря a2 и y-глобулинам в течение периода разгара (Marinescu).
Патологоанатомическое исследование при остром инфекционном лимфоцитозе, производимое в крайне редких случаях, выявляет синусную ретикулярную гипоплазию, которая может доходить до блокирования синусов, с легкой гипоплазией, до дегенерации в герминативных центрах.
Спленическая пункция не показывает изменений (Berceanu и Gociu). Циркулирующие лимфоциты повидимому происходят либо из костного мозга, либо из пластинок Реуег, либо из легочных лимфоидных образований. В спинномозговой жидкости была найдена лишь в одном случае гиперцеллюлярность с лимфоцитозом.
С иммуносерологической точки зрения не было найдено до сих нор никаких изменений. Реакции на гетерофильные антитела — отрицательные.
Положительный диагноз ставится на основе эпидемиологических данных и гематологической картины.
Дифференциальный диагноз острого инфекционного лимфоцитоза следует ставить по отношению к следующим заболеваниям:
а) инфекционный мононуклеоз, при котором появляется симптоматическая триада — лихорадка + адепопатии + ангина; присутствуют атипичные мононуклсарные клетки, а серологические тесты на гетерофильные антитела — позитивные;
б) хроническая лимфатическая лейкемия, при которой наблюдается лимфоаденоспленомегалия и специфическая инфильтрация костного мозга у больных более преклонного возраста;
в) острая лимфобластическая лейкемия, характеризующаяся наличием молодых аномалийных бластических клеток в периферической крови и в костном мозге, а также и сопровождающей ее анемией и тромбопенией;
г) коклюш, отличающийся наличием приступообразного кашля и отсутствием лимфоцитарного инфильтрата в костном мозге;
д) физиологический гиперлимфоцитоз грудного ребенка и маленького ребенка — лишенный каких-либо симптомов;
е) длительные постинфекционные хронические лимфоцитозы, при которых сама история болезни уясняет диагноз;
ж) различные лейкемоидные реакции, при которых присутствуют атипичные незрелые клетки;
з) острый аппендицит, который может симулировать гастроиптестинальную форму, однако гемограмма без периферического лимфоцитоза уясняет диагноз;
и) различные инфекции верхних дыхательных путей, особенно вирусные, но при которых не существует периферического лимфоцитоза, как при дыхательной форме острого инфекционного лимфоцитоза;
к) высыпные заболевания, как например корь, краснуха, roseola infantum, скарлатина, которые распознаются на основе характерных признаков этих заболеваний, отсутствующих при кожной форме острого инфекционного лимфоцитоза.
Лечение острого инфекционного лимфоцитоза, в основном не нужно и даже бесполезно. В случае необходимости надо бороться с мучительными симптомами при помощи жаропонижающих, седирующих, противокатарральных средств, витаминотерапии. В случае инфекционных осложнений применяются антибиотики, а к кортизонотерашш и АКТГ надо прибегать в случае форм с тяжелым нервным синдромом, впрочем чрезвычайно редких.
Лимфоцитоз
Лимфоцитоз – это увеличение содержания лимфоцитов выше 4000 (или 40%) в 1 мкл крови. Причиной выступают острые вирусные заболевания, некоторые хронические бактериальные инфекции, злокачественные гематологические болезни и т.д. Клинические проявления определяются нозологией, на фоне которой развился лимфоцитоз. Уровень лимфоцитов исследуется в венозной или капиллярной крови при подсчете лейкоцитарной формулы общего анализа крови. Для коррекции лимфоцитоза проводится борьба с причиной, т.е. лечение основного заболевания.
Нет четких числовых критериев разделения лимфоцитоза по степени выраженности. Условно выделяется умеренный (до 60%) и высокий лимфоцитоз (больше 60%). Основной причиной высокого лимфоцитоза считаются злокачественные болезни кроветворной и лимфатической ткани. Лимфоцитоз, как и другие виды лейкоцитоза, подразделяется на:
- Абсолютный. Под абсолютным лимфоцитозом подразумевается увеличение количества лимфоцитов наряду с общим числом лейкоцитов (у взрослых более 4000, у детей до 5 лет более 6000).
- Относительный. Относительный лимфоцитоз встречается намного чаще и означает процентное возрастание лимфоцитов (больше 40%) на фоне нормального или даже пониженного общего числа лейкоцитов.
Причины лимфоцитоза
Физиологические состояния
Наиболее яркий пример - физиологический лимфоцитоз у детей в возрасте до 4-5 лет. Причина данного явления связана с возрастными изменениями в иммунной системе ребенка. С 7 дня жизни у детей начинается активный рост количества лимфоцитов (до 55-60%) и падение нейтрофилов (первый перекрест лейкоцитарной формулы). Затем к 4 годам лимфоциты возвращаются к показателям, как у взрослых (до 40%), а нейтрофилы, напротив, увеличиваются (второй перекрест). Патологическим лимфоцитозом у детей следует считать цифры больше 60%.
Отдельно выделяют кратковременные лимфоцитозы, не связанные ни с каким заболеванием. Среди таких причин лимфоцитоза:
- Стресс.
- Алиментарные факторы: голодание, следование вегетарианской диете.
- Использование лекарственных препаратов: фенитоина, пара-аминосалициловой кислоты, наркотических анальгетиков.
Лимфоциты являются основным «орудием» иммунной системы против вирусов. Они вырабатывают специальные антитела (иммуноглобулины), которые, связываясь с вирусом, препятствуют его проникновению в клетки. В дальнейшем вирусные частицы подвергаются фагоцитозу. Другой механизм противовирусного иммунитета – уничтожение клеток, зараженных вирусной ДНК или РНК, путем запуска запрограммированной клеточной гибели (апоптоза). Сходным образом лимфоциты борются с некоторыми бактериями, внутриклеточными паразитами (токсоплазмами).
- Острые вирусные инфекции. Наиболее частой причиной лимфоцитоза у детей признаны такие инфекционные заболевания как корь, краснуха, ветряная оспа; у взрослых – грипп, ОРВИ. Обычно лимфоцитоз умеренный, он возникает резко, достигает максимума параллельно разгару заболевания, затем по мере разрешения симптомов быстро возвращается к нормальным значениям.
- Инфекционный мононуклеоз. Специфической вирусной инфекцией у детей является инфекционный мононуклеоз, вызываемый вирусом Эпштейн-Барра. При инфекционном мононуклеозе лимфоцитоз более стойкий, может сохраняться несколько недель или месяцев. Иногда вирус персистирует годами и может стать причиной синдрома хронической усталости.
Помимо количественных изменений, вирусные инфекции считаются причиной появления атипичных мононуклеаров (вироцитов) – лимфоцитов, имеющих разную форму, измененную структуру ядра, базофильную цитоплазму. В незначительных количествах (менее 10%) они присутствуют при любых вирусных инфекциях. Более высокая концентрация таких клеток (более 10%) свидетельствует об инфекционном мононуклеозе.
У взрослых одна из частых причин лимфоцитоза – бактериальные инфекции с хроническим течением, сопровождающиеся образованием специфических эпителиоидных гранулем (туберкулез, бруцеллез, сифилис). Реже причиной лимфоцитоза у взрослых выступают тифозные заболевания (брюшной, сыпной тиф, паратифы). Единственной острой бактериальной инфекцией, вызывающей лимфоцитоз у детей, считается коклюш.
В основном наблюдается незначительный лимфоцитоз, причем практически всегда относительный, на фоне общей лейкопении. В виду хронического течения болезней лимфоцитоз может сохраняться неопределенно долго (месяцы, годы), увеличиваясь в периоды обострения. При туберкулезе лимфоцитоз свидетельствует о доброкачественном течении и считается предиктором благоприятного исхода.

Злокачественные болезни крови
Наиболее опасной причиной лифмоцитоза у взрослых и детей признаны миелопролиферативные и лимфопролиферативные заболевания. В таких случаях лимфоцитоз обусловлен пролиферацией опухолевых клонов лимфатической ткани или злокачественной трансформацией кроветворных клеток в костном мозге. У взрослых в основном наблюдаются хронический лейкоз, неходжкинские лимфомы (лимфосаркомы). У детей чаще встречается лимфогранулематоз (лимфома Ходжкина). Лимфоцитоз достигает очень высоких цифр (до 70-90%).
Нарастание лимфоцитоза происходит постепенно: максимальное значение достигается через несколько лет, уменьшается медленно, только под действием курсов химиотерапии. Быстрый возврат к нормальным показателям возможен только при пересадке костного мозга. Помимо лимфоцитоза, отмечаются такие признаки, как одновременное увеличение эозинофилов и базофилов (базофильно-эозинофильная ассоциация), присутствие большого количества бластов, промежуточных форм (пролимфоцитов).
Эндокринные расстройства
В некоторых случаях причиной лимфоцитоза становятся заболевания эндокринных органов. Точный механизм данного явления до сих пор окончательно не установлен. Умеренная степень лимфоцитоза часто развивается одновременно с увеличением концентрации эозинофилов. У взрослых такая картина наблюдается при акромегалии, тиреотоксикозе, недостаточности коры надпочечников. У детей частой причиной становятся врожденные дисфункции половых желез. Лимфоцитоз быстро регрессирует после назначения заместительной гормональной терапии.
Другие причины
- Ревматологические патологии: ревматоидный артрит, острая ревматическая лихорадка, системная красная волчанка.
- Болезни крови: апластическая анемия, В12-фолиево-дефицитная анемия, посттрансфузионный синдром.
- Паразитарные инвазии: малярия, болезнь Шагаса, шистосомоз.
- Аллергические реакции: бронхиальная астма.
Уровень лимфоцитов измеряется при клиническом анализе крови. В виду того, что лимфоцитоз имеет достаточно широкий этиологический спектр, при его обнаружении следует обратиться к специалисту широкого профиля (терапевту или педиатру), чтобы тот на основании жалоб пациента, анамнестических данных, физикального осмотра, назначил дополнительное обследование, которое может включать:
- Анализы крови. Проводится подсчет лейкоцитарной формулы для определения процентного соотношения всех форм лейкоцитов. Методом микроскопии изучается мазок крови для выявления атипичных мононуклеаров, теней Боткина-Гумпрехта (остатков разрушенных лимфоцитов). Определяются воспалительные маркеры – повышенные СОЭ, СРБ. Для обнаружения опухолевых антигенов выполняется иммунофенотипирование, иммуногистохимичекое исследование.
- Идентификация возбудителя. С целью выявления инфекционного агента выполняются тесты на наличие антител к патогенам, их ДНК (методом ИФА, ПЦР). Проводятся бактериологические исследования – посев, микроскопия мокроты (туберкулез, коклюш), серологическая диагностика – реакция Райта, Хеддельсона (бруцеллез), реакция микропреципитации (сифилис).
- Инструментальные исследования. При туберкулезе на рентгенограмме легких отмечается увеличение прикорневых, медиастинальных лимфатических узлов, инфильтрация верхних долей легких, иногда выпот в плевральную полость. При мононуклеозе и гемобластозах на УЗИ брюшной полости обнаруживается выраженная спленомегалия, реже гепатомегалия.
- Гистологические исследования. При хроническом лимфолейкозе в пунктате костного мозга находят большое количество лимфобластов. При лимфомах в биоптате лимфоузла, полученном путем тонкоигольной аспирации, выявляется диффузная пролиферация лимфоидных клеток с бластной морфологией. Специфический признак лимфогранулематоза – гигантские клетки Березовского-Штернберга.

Прямых способов нормализации концентрации лимфоцитов не существует. Для борьбы с лимфоцитозом необходимо лечить основную патологию, послужившую причиной повышения лимфоцитов. Незначительный кратковременный лимфоцитоз, возникший на фоне стресса, приема лекарственных препаратов или в период выздоровления от простудного заболевания, не требует терапии. В случае долговременного лимфоцитоза, как абсолютного, так и относительного, необходимо обратиться к врачу.
Для многих вирусных инфекций (ветряной оспы, краснухи, ОРВИ) на сегодняшний день не разработано этиотропной терапии. Для их лечения применяются патогенетические и симптоматические методы – обильное горячее питье, жаропонижающие, противовоспалительные лекарства. При катаральном синдроме назначаются полоскание и орошение горла антисептическими растворами, спреями. В первые дни гриппа эффективно использование противовирусных препаратов (осельтамивир, римантадин).
Имеются данные о снижении количества осложнений инфекционного мононуклеоза у взрослых путем назначения ацикловира, валцикловира. При бактериальных инфекциях прописывают антибиотики, при туберкулезе – комбинацию противотуберкулезных средств. Если причиной лимфоцитоза стало лимфопролиферативное заболевание, то требуется проведение длительных повторных курсов химиотерапии. При неэффективности консервативного лечения хронического миелолейкоза у взрослых прибегают к аллогенной трансплантации костного мозга.
В ряде случаев уровень лимфоцитов может быть ориентиром для прогнозирования развития заболевания. Например, лимфоцитоз при туберкулезе, как у детей, так и у взрослых, свидетельствует о благоприятном течении болезни и о скором выздоровлении. И наоборот, если причиной чрезмерного увеличения лимфоцитов выступают злокачественные гематологические заболевания, это косвенно может говорить о высокой вероятности летального исхода. Однако в первую очередь необходимо ориентироваться на основную патологию и ее тяжесть. Поэтому любая степень лимфоцитоза требует тщательного обследования для установления причины и своевременной терапии.
1. Патофизиология системы крови. Часть II. Нарушения в системе лейкоцитов/ Николаева О.В., Кучерявченко М.А., Шутова Н.А. и др. – 2016.
4. Синдромная диагностика и базисная фармакология заболеваний внутренних органов. Т. 2/ под ред. Федосеева Г.Б., Игнатова Ю.Д. – 2004.
Читайте также:
- Иммуноэлектрофорез плазмы, биологических жидкостей, парапротеинов - принципы, эффективность
- Рентгенограмма, КТ при множественной миеломе челюсти
- Классификация плевральных сращений. Типы плевральных сращений
- Поражение височно-нижнечелюстного сустава (ВНЧС) при болезни депонирования пирофосфата кальция дигидрата - лучевая диагностика
- Показания для операции при нестабильности плечевого сустава
